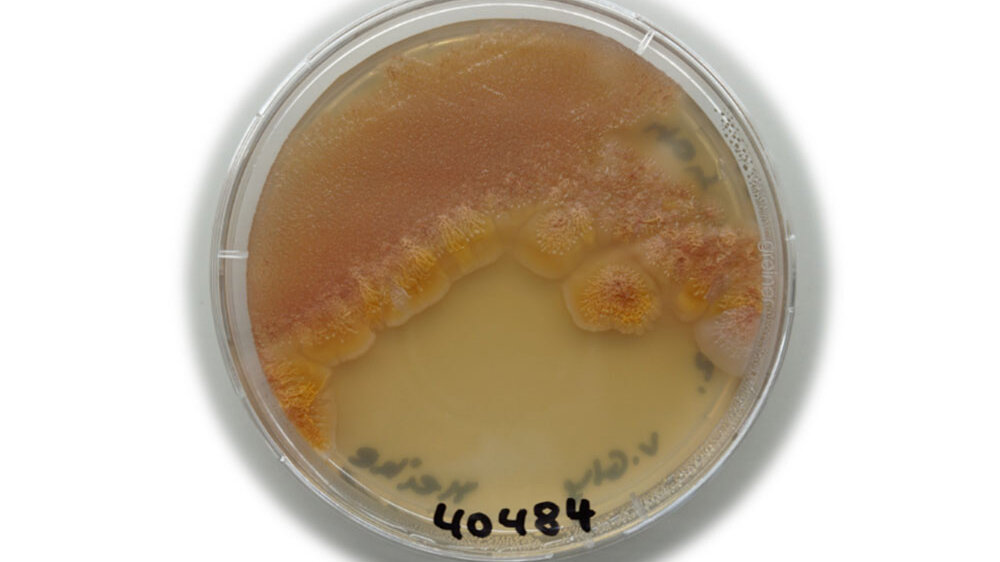
Bakterienkultur DSMZ

Die Deutsche Sammlung von Mikroorganismen und Zellkulturen GmbH dient nicht nur zur Erhaltung der Artenvielfalt, sondern ist auch eine nützliche Quelle für medizinisch und biotechnologische Produkte. Das DSMZ untersucht jeden Mikroorganismus genauestens vor der Aufnahme in die Sammlung und die Forschenden notieren dazugehörige Eigenschaften. Nun haben Forschende um Prof. Dr. Yvonne Mast und Dr. Imen Nouioui seit 40 Jahren eingelagerte Bakterien mittels neuester Technologien erneut untersucht und interessante Entdeckungen gemacht.
Neue Untersuchungsmethoden – neue Erkenntnisse
Die Gruppe um Mast und Nouioui untersuchte fünf Bakterien der Gattung Streptomyceten. Eine Mehrheit der eingesetzten Antibiotika werden von diesen Bakterien hergestellt und sie sind bereits bekannte Wirkstoffproduzenten. In der neuen Untersuchung identifizierten die Forschenden fünf Streptomyceten-Stämme als neue Spezies. Durch den Prozess des Genome Minings stellte man fest, dass die neuen Stämme ebenfalls Antibiotika herstellen können.
„Unsere Untersuchung verdeutlicht, wie wichtig das kontinuierliche Sammeln von Bioressourcen für die Wissenschaft ist, da durch die Verwendung neuer Technologien „alte Bioressourcen“ weiter an Wert gewinnen können“, erklärt Prof. Mast. „Darüber hinaus besitzen diese Bakterien noch zahlreiche weitere Biosynthesegencluster, die wenig Ähnlichkeit zu bereits bekannten Genclustern besitzen. Das deutet darauf hin, dass sie potentiell neuartige Naturstoffe produzieren könnten“, ergänzt Mast.
Ehrung bekannter Mikrobiologen

Ihre neuen Entdeckungen nutzten die Forschenden als Chance, bedeutende deutsche Mikrobiologen zu ehren. Denn in der Mikrobiologie können Mikroorganismen nach bekannten Persönlichkeiten aus der Wissenschaft benannt werden. So zollten Mast und Nouioui unter anderem zwei ehemaligen Wissenschaftlern des DSMZ ihre Hochachtung durch die Benennung der neuen Stämme. Prof. Dr. Erko Stackebrandt ist Namensgeber für Streptomyces stackebrandtii und war selbst Leiter des DSMZ von 1993 bis 2010.
Eine weiterer Stamm wurde nach Prof. Dr. Reiner Maria Kroppenstedt benannt (streptomyces kroppenstedtii). Er arbeitete von 1979 bis 2007 am DSMZ und prägte den Sammlungsbereich der Actinobakterien maßgeblich.
Quelle: DSMZ
Artikel teilen